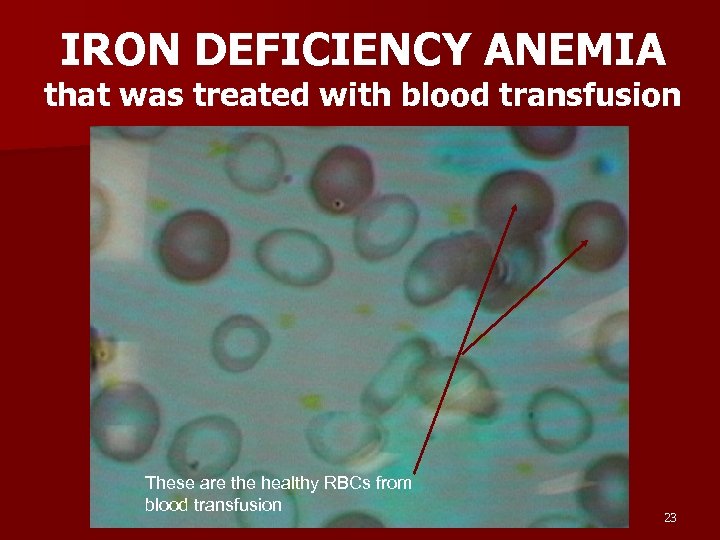
IRON DEFICIENCY ANEMIA that was treated with blood transfusion These are the healthy RBCs
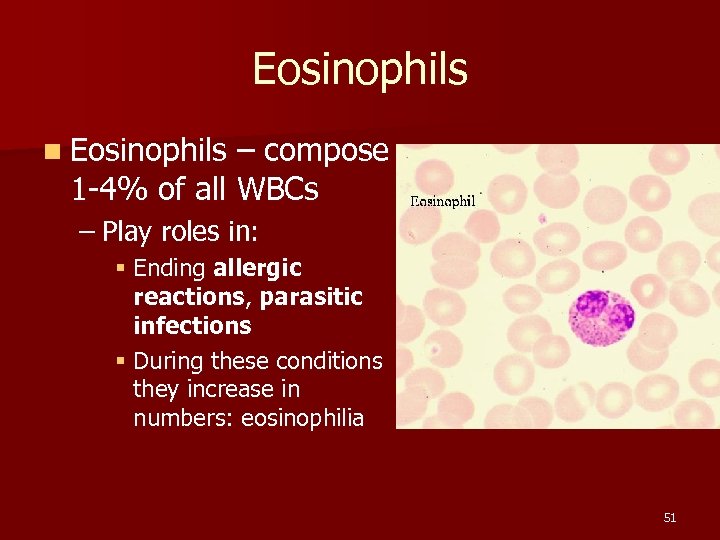
Eosinophils n Eosinophils – compose 1 -4% of all WBCs – Play roles in:
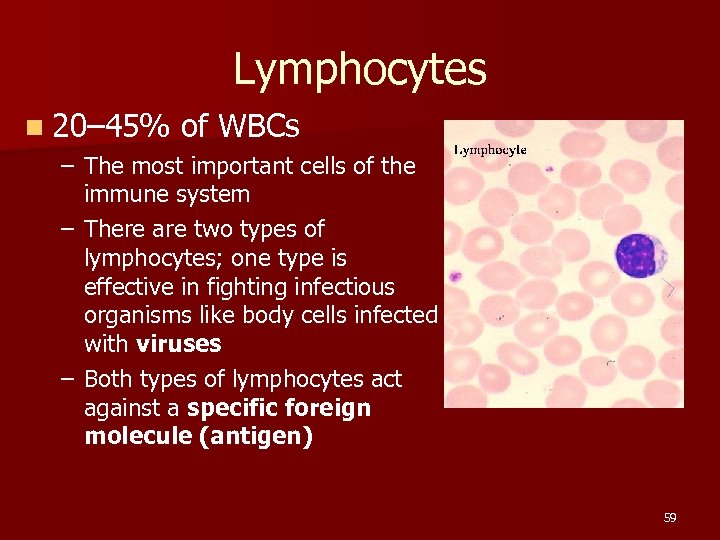
Lymphocytes n 20– 45% of WBCs – The most important cells of the immune
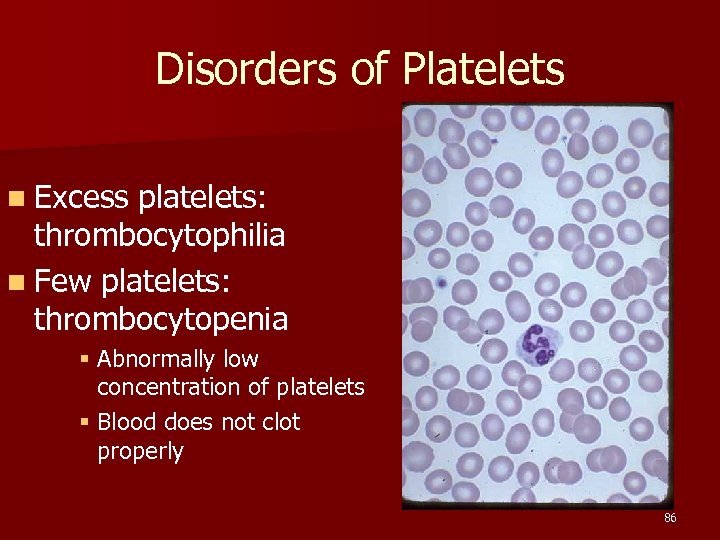
Disorders of Platelets n Excess platelets: thrombocytophilia n Few platelets: thrombocytopenia § Abnormally low

a28bdee8531f430294b065528a616420.ppt
- Количество слайдов: 109

Blood 1

Blood n Blood is not an epithelial tissue, and it’s not loose or dense connective tissue; it’s classified as a “special connective tissue”. n You have about 5 liters of blood, but that is only half of the body fluid. n The other half includes fluid around each cell, and joint fluids, etc. 2

Blood plasma circulates outside of the blood vessels too! PLASMA EXTRACELLULAR FLUID ↑↓ ↓↑ ↓↑ SYNOVIAL FLUIDS STOMACH CSF 3

Blood consists of the following: n Plasma n Red blood cells n White blood cells n Platelets 4

FUN FACTS n In one day, your blood travels nearly 12, 000 miles. n Your heart beats around 35 million times per year. Your heart pumps a million barrels of blood during the average lifetime -- enough to fill three supertankers. If an artery is cut, blood will shoot out 30 feet. 5

Plasma is what the blood cells float around in. If you spin a blood sample in a test tube, the red blood cells sink to the bottom, and you’ll see the yellow plasma on top. n Some people who need blood just need the packed RBCs (anemia), some need the platelets (hemophilia), others need the plasma (burn victims), and some need whole blood (hemorrhage), which is both plasma and RBCs. n 6

Overview: Composition of Blood Figure 17. 1 7

8

PLASMA CONTENTS Water (90%) Dissolved substances (10%) n n – Proteins § § – Nutrients § § – – – Albumin (egg white). Most common protein in blood (needed for homeostasis of blood volume) Antibodies Clotting factors; main one is called fibrin. Lipoproteins (move fats through blood: HDL, LDL) Glucose (main energy source) Amino Acids (builds proteins) Wastes (urea) Gases (O 2, CO 2, Nitrogen) Electrolytes = ions (Na+, K+, Cl-, Ca++) 9

Blood Cells 10

ERYTHROCYTES (Red blood cells) 5 million n Like a doughnut with the hole not fully cut out. n – These are among the smallest cells in the body – They have no nucleus – Biconcave to increase surface area – Filled with hemoglobin (Hgb), which carries O 2 throughout the body. Oxygenated Hgb is bright red, deoxy Hgb is deeper red, almost 11 a bluish-purple.

Erythrocytes 12

Hemoglobin Molecule 13

Hemoglobin Molecule Hemoglobin consists of 2 alpha units and 2 beta units. Hemoglobin abnormalities are classified by which unit is deformed. The heme group is where the oxygen molecule binds. An iron (Fe++) molecule is in the middle, which attracts the oxygen to the heme group. 14

ERYTHROCYTES: – Average life span is 120 days. Old ones are destroyed in the spleen and liver, and Hgb and iron are recycled. – In one day, 100 billion of these cells are destroyed, and 100 billion are made: where? – Red bone marrow. 15

Disorders of RBCs Polycythemia n Anemia – Too few RBC’s – Iron deficiency – Hemorrhagic anemia (person lost blood) – Hemolytic anemia (immune disorder, infection, blood transfusion) § G 6 PD deficiency – Hemoglobin abnormalities § Pernicious (Megaloblastic) anemia (lack of vitamin B 12 or intrinsic factor) § Thalassemia § Sickle cell disease n 16

Polycythemia Too many RBC’s; can cause clots. Need therapeutic phebotomy. 17

ANEMIA n Any condition of RED BLOOD CELLS in which the blood’s capacity for carrying oxygen is diminished. n HYPOXIA is lack of oxygen to tissues. – It can be caused from: § Ischemia (reduced blood flow to a tissue) § Malfunctioning hemoglobin § Increasing altitude 18

Anemia Characteristic sign of anemia: see reticulocytes in the blood (immature red blood cells). n Remnants of the nucleus are still in the cell. n 19

Reticulocytes 20

Anemia can be caused by many things. One type of anemia is from too few RBC’s. 21

Anemia can also be caused from Iron Deficiency 22
IRON DEFICIENCY ANEMIA that was treated with blood transfusion These are the healthy RBCs from blood transfusion 23

Hemolytic Anemia n Hemolysis means rupture of RBC’s. – Hereditary (born with the genes that cause the disease) § Immune disorders and G 6 PD deficiency. – Acquired § Infections (malaria and ebola virus), and receiving the wrong blood type in a transfusion. 24

G 6 PD Deficiency Hereditary, X-linked; almost all are males n G 6 PDH is an enzyme which is important for RBC metabolism. n G 6 PD is the most common human enzyme defect. n A person with this develops hereditary (NOT acquired) hemolytic anemia in response to a number of causes, most commonly infection or exposure to certain medications, chemicals, or ingestion of fava beans. 25

HEMOGLOBINOPATHIES n Pernicious anemia (megaloblastic anemia) n Thalassemia n Sickle Cell Disease 26

Pernicious anemia (megaloblastic anemia) Caused by lack of vitamin B 12 or intrinsic factor n When a person has gastric bypass surgery, the stomach is no longer able to produce intrinsic factor, which is needed to absorb vitamin B 12, which is needed to make hemoglobin in RBC’s. n Without this vitamin, the blood cells are fewer and much larger than normal (megaloblastic). n The surgery patient must take vitamin B 12 shots or sublingual supplements for the rest of their life. n 27

Megaloblastic Anemia (Large RBCs: Note that the lymphocyte is the same size as the huge RBCs) 28

Thalassemia A hereditary form of anemia where the RBCs have abnormal hemoglobin that deforms the cells into a variety of bizarre shapes TEAR DROP TARGET CELLS SPHEROCYTE 29

Sickle Cell Disease n Present in African Americans more than in other groups, and is always characterized by sickled erythrocytes. n The sickle shape helps prevent malaria infections, but it also causes blood clots. 30

Sickle Cell Anemia SICKLE CELL 31

RBC, Hgb, Hct n Red blood cell (RBC) count is a count of the actual number of red blood cells per volume of blood. Both increases and decreases can point to abnormal conditions. n Hemoglobin (Hgb) measures the amount of oxygencarrying protein in the blood. n Hematocrit (Hct) measures the percentage of red blood cells in a given volume of whole blood. 32

Hematocrit n n n A quick screening test for anemia is the hematocrit. A drop of blood is drawn up a small glass capillary tube and the tube is centrifuged to pack the red blood cells at the bottom with the plasma on top. Hematocrit measures the percentage of blood volume that consists of erythrocytes. The hematocrit is the ratio of packed red blood cells to total blood volume. Normal is about 45% (46% for men and 38% for 33 women. )

Hematocrit 34

Blood Doping n Blood doping is the practice of boosting the number of red blood cells in the bloodstream (by receiving donated blood) in order to enhance athletic performance. n Because such blood cells carry oxygen from the lungs to the muscles, a higher concentration in the blood can improve an athlete’s aerobic capacity and endurance. 35

IOC strips Lance Armstrong of Olympic medal n The winner of seven straight Tour de France titles confessed to Oprah Winfrey to using blood doping during that time. n Two months after the France tournament, he won the bronze medal at the 2000 Sydney Games. n Olympic officials won a suit to have the medal returned. 36

Lance Armstrong (right) 37

BLOOD TYPING: The ABO SYSTEM n Blood typing is the technique for determining which specific protein type is present on the RBC membranes. n Only certain types of blood transfusions are safe because the cell membranes of the red blood cells carry certain types of proteins that another person’s body will think is a foreign body and reject it. 38

BLOOD TYPING n n n These proteins are called antigens (something that causes an allergic reaction). There are two types of blood antigens: Type A and Type B. A person with Type A antigens on their blood cells have Type A blood. A person with Type B antigens have Type B blood. A person with both types has type AB blood. A person with neither antigen has type O blood. 39

40

BLOOD TYPING n n n If a person with type A blood gets a transfusion of type B antigens (from Type B or Type AB, the donated blood will clump in masses (coagulation), and the person will die. The same is true for a type B person getting type A or AB blood. Type O- blood is called the universal donor, because there are no antigens, so that blood can be donated to anyone. Type AB+ blood is considered the universal acceptor, because they can use any other type of blood. This blood type is fairly rare. The rarest blood type is AB negative. 41

RH FACTOR n There is another term that follows the blood type. The term is “positive” or “negative”. This refers to the presence of another type of protein, called the Rh factor. A person with type B blood and has the Rh factor is called B positive. n A person with type B blood and no Rh factor is called B negative. 42

RH FACTOR n The reason this is so important is that if an Rh- mother has an Rh+ fetus in her womb (from an Rh+ father), her antibodies will attack the red blood cells of the fetus because her body detects the Rh protein on the baby’s red blood cells and thinks they are foreign objects. This is called Hemolytic Disease of the Newborn (HDN). 43

44

HDN n This can be prevented if the doctor knows the mother is Rh- and the father is Rh+, because that means the baby has a 50% chance of being Rh+ like the father. n Therefore, anytime a mother is Rh-, even if the mother says the father is Rh-, you can’t be sure who the father is, so they will proceed as though the baby may be Rh +. n They will give her an injection of a medicine (Rhogam) that will prevent her immune system from attacking the baby. 45

Rhogam n n n The baby does not make the Rh factor until about 18 weeks into the pregnancy. Rhogam is given at 18 weeks into the pregnancy and again within 72 hours after giving birth. It is usually given within 2 hours after giving birth since you can’t trust the patient to return after they leave the hospital. The first baby is not at risk; during the first birth (or miscarriage), the placenta tears away and that’s when the baby’s blood cells get into the mother’s bloodstream. She then forms antibodies against the Rh factor, which are ready to attack the second fetus. 46

Kell Proteins The Kell protein is another antigen on some people’s RBC’s, similar to the Rh factor. People either have big K or little k proteins. Most people have little kk. If one parent has big K (either Kk or KK), the child can get Hemolytic Disease of the Newborn. n This is probably the disease that was in the genes of Henry VIII (probably had Kk), which caused most of his children to become weak and die in infancy. He could only safely have children with those women who were either Kk or KK (about 9% of the population). 47 n

Reynolds. Unwrapped. com offers FANTASTIC, inexpensive daily email subscriptions, where you can receive a HILARIOUS new cartoon every day, and it is a MARVELOUS idea for a UNIQUE gift for your family and friends as well. That is how I learned about this. . . one of my fellow teachers gave me a subscription as a birthday present. He also has FUNNY greeting cards and BEAUTIFUL paintings for sale as well. You can also get reprints suitable for framing, or originals. Here is more info about his work and a YOUTUBE video. https: //nccnews. expressions. syr. edu/? p=11515 48

LEUKOCYTES (White blood cells) all fight infection n BASOPHILS – MAST CELL EOSINOPHILS n NEUTROPHILS n MONOCYTES n – MACROPHAGES n LYMPHOCYTES – B CELLS – T CELLS too many is ___philia too few is ___penia 49

BASOPHILS n Basophils – only about 0. 5% of all leukocytes – Granules secrete histamines (vasodilation; more WBCs can get to the infection site) – Antihistamines interfere with the function of basophils. – Mast Cell: a basophil that leaves the blood vessel and enters the tissues. 50
Eosinophils n Eosinophils – compose 1 -4% of all WBCs – Play roles in: § Ending allergic reactions, parasitic infections § During these conditions they increase in numbers: eosinophilia 51

Neutrophils n Neutrophils – most numerous WBC n First to respond to infection – Phagocytize and destroy bacteria – Also destroy bacterial toxins in body fluids – Nucleus – has two to six lobes 52

White Blood Cell Phagocytosis n VIDEO n http: //www. youtube. com/watch? v=Jnl. ULOj. Uh. SQ 53

Neutrophils n Neutrophils are the white blood cells that contribute to immunity mainly by engulfing BACTERIA and foreign bodies (thorns, dirt, etc) in a process called phagocytosis. n They release the contents of their lysosomes onto the invader, dissolving it. n When a bacterium has a capsule, it makes it hard to phagocytize, so the neutrophil requires opsonization by antibodies. 54

Opsonization n Some bacteria have evolved a slippery capsule around them as a defense against phagocytosis. The neutrophil cannot engulf this type of bacteria. Neither can a macrophage. n When an antibody attaches to this type of bacteria, the neutrophil can now grab onto the antibody like a handle, enabling it to phagocytize the bacteria. n This process of facilitation of phagocytosis is called opsonization. 55

n n When an invading bacteria has the antibody attached to its cell membrane, the entire structure is now called an antigen-antibody complex. If a bacterium does not have a capsule, the neutrophil can destroy it without opsonization. The antibody can also destroy the bacterium by itself by popping the cell membrane. But when a capsule is present, the neutrophil and antibody work best together. Neutrophils are also the ones that primarily destroy the dissolved toxins that bacteria secrete into body fluids. 56

Monocytes Comprise about 5% of all WBC’s. n Like neutrophils, they phagocytize (eat) bacteria, old cells, and foreign bodies. They have more types of lysosome enzymes than neutrophils so they are better at killing difficult pathogens. n They also use antibodies for opsonization. n When they leave the bloodstream and enter the tissues, they are called MACROPHAGES. n 57

WBC’s leave the blood vessel to enter the tissues 58
Lymphocytes n 20– 45% of WBCs – The most important cells of the immune system – There are two types of lymphocytes; one type is effective in fighting infectious organisms like body cells infected with viruses – Both types of lymphocytes act against a specific foreign molecule (antigen) 59

Lymphocytes n Two main classes of lymphocyte – – B cells – Originate in the bone marrow, mature into plasma cells. A mature plasma cell fights infection by producing antibodies T cells – Originate in the thymus gland. They attack foreign cells directly (including organ transplants!). They can also kill viruses. 60

Lymphocytes B cells – mature into plasma cells n Plasma cells secrete antibodies; the plasma cell’s antibodies are what kills the attacking cell. n Antibodies attack in three ways: – They attach to bacteria and pop the cell membrane – They attach to encapsulated bacteria to help neutrophils and macrophages to phagocytize them. – They agglutinate (clump all over the bacteria, binding their receptor sites so they cannot cause harm) n 61

Disorder of B-cell Lymphocytes Mononucleosis: Epstein Barr virus attacks B lymphocytes. It is characterized by inflammation of lymph vessels (lymphangitis). n – Lymphangitis: lymph vessel inflammation; usually from infection. Infected lymphocytes have a characteristic scalloped edge where they touch RBC’s 62

Function of a B Lymphocyte Figure 17. 6 b 63

T-cell Lymphocytes n n n T cells – coordinate the immune response by recruiting other white blood cells. They can directly destroy bacteria by popping their cell membrane. T cells can also directly destroy foreign cells by popping the cell membrane. They do not need to phagocytize the invading cell. They do not need the assistance of antibodies. T-cells can therefore kill a body cell that has become infected with viruses. 64

T-Cell 65

T-cell Lymphocytes n T cells are the cells that attack organ transplants! § § § Immunosuppression drugs are designed to inhibit the action of T cells are attacked by the HIV (AIDS) virus. The thymus gland secrets certain hormones which can cause T cells to become immunocompetent (makes the cells mature and start to work) 66

T Cells There are several types of T cells. The main types are Cytotoxic (Killer) T cells – Go out and directly kill bacteria or infected host cells n Helper T cells – Release chemicals called “cytokines” to call in more white blood cells of all types to join in the war. They also present the macrophage’s antigen to a B cell, which causes it to produce antibodies against that particular bacteria. The B cell is now called a plasma cell n Suppressor T cells – Stop the immune process when it is over. n 67

Killer TCell 68

Virus-Infected Cell 69

Function of a T- Lymphocyte Figure 17. 6 a 70

Y Y Pops cell Y Opsonization YY Virus in body cell Bacteria Y Plasma Cell Phagocytosis Y YYY Antibodies Bacteria Pr es Agglutinates Y Capsule Memory B cell Pops the cell Cytokines STOP en ta tio n Presentation Neutrophil Macrophage (Monocyte in bloodstream) B-Cell Helper T-Cell Killer T-Cell Lymphocytes Suppressor T-Cell 71

LEUKEMIA Cancer of the blood is called leukemia. It actually only involves the white blood cells. n Something goes wrong in one stem cell, and it starts making huge amounts of clones of itself which don’t work right and not enough normal white blood cells are made. Therefore, the body cannot fight infection. So, the immature white cells are sent into the bloodstream. It’s better to send a young cell with no weapons to the war than to send nothing at all! n Think of Leukemia as too few mature white blood cells. n Even though the WBC count is high, they are all immature forms. n 72

Disorders of WBCs n Disorders of leukocytes – Leukemia – too few mature WBC’s (may see increase in immature forms); a form of cancer – Classified as lymphoblastic (too many immature lymphocytes) or myeloblastic (too many immature neutrophils) 73

Bone Marrow Transplant People with severe leukemia may need a bone marrow transplant. n First, all of their WBC’s have to be killed off with a medicine because they are mostly malfunctioning anyway. n A donor has a small cylinder of bone removed from their hip. This is ground up and given by i. v. to the recipient. n The new WBC’s may kill the patient or it may save their life. It is done as a last resort. n 74

WBC Count n White blood cell (WBC) count is a count of the actual number of white blood cells per volume of blood. Both increases and decreases can be significant. n White blood cell differential looks at the types of white blood cells present. There are five different types of white blood cells, each with its own function in protecting us from infection. The differential classifies a person's white blood cells into each type: neutrophils (also known as segs, PMNs, granulocytes, grans), lymphocytes, monocytes, eosinophils, and basophils. 75

Antibodies (also known as immunoglobulins, abbreviated Ig) are proteins made by plasma cells. n They are used to identify and neutralize foreign objects, such as bacteria and viruses. n They are typically made of basic structural units —each with two large heavy chains and two small light chains—to form a unit shaped like the letter “Y” n 76

A Typical Antibody The tips of the “Y” have receptors that are specific for a particular antigen. The stem of the “Y” can be grasped by a phagocyte. 77

#1 #2 #3 Precipitation/agglutination 78

IMMUNITY n Most people are sick more often as children than as adults in their 20 s through 30 s because we build up many varieties of memory lymphocytes during childhood, providing immunity from more and more antigens during adulthood. 79

PLATELETS (thrombocytes) Very small compared to all other blood cells. These are pieces of another cell found in the red marrow called a MEGAKARYOCYTE. n Pieces break off of a megakaryocte and are known as platelets. n When a platelet encounters a broken blood vessel it uses clotting factors (made in the liver and circulating in the blood) to form a web to clots blood. n Platelets are responsible for clot formation. n 80

Platelets n Cell fragments – Break off from megakaryocytes n Function blood in clotting of Platelets Megakaryocyte 81

Platelets need certain proteins in the plasma called CLOTTING FACTORS in order for them to become activated and form a clot. n The main clotting factor is called FIBRIN, but there are many other types as well. 82

Blood Clot 83

Vitamin K n Found in green, leafy vegetables. n Needed for blood clotting factors. n Some types of rat poisons work by eliminating the blood clotting ability. n In case of accidental ingestion of rat poison, a child needs an I. V. of vitamin K. n It works for accidental poisoning in dogs, too! 84

Aspirin One baby aspirin a day can help prevent blood clots. n It blocks the ability of an enzyme called COX (cyclo-oxidase) to make a substance called prostaglandin. n Prostaglandins are needed for inflammatory reactions. However, they also INCREASE blood clotting time. n 85
Disorders of Platelets n Excess platelets: thrombocytophilia n Few platelets: thrombocytopenia § Abnormally low concentration of platelets § Blood does not clot properly 86

HEMOPHILIA A hereditary disease of males, where they are unable to clot properly because they are missing some clotting factors. n When they get even a slight bump or bruise they have to have an intravenous infusion of clotting factors or they will bleed to death. n 87

Blood Clots n Thrombus – A clot in a vessel n Embolism – a thrombus that broke away and travels in the blood stream. – It usually lodges in a smaller blood vessel and blocks circulation distal to that point. 88

Blood Clots n Thrombus n Embolism 89

Thrombus 90

Thrombus 91

Prothrombin Time (PT) and Partial Thromboplastin Time (PTT) n The PTT test is used to investigate unexplained bleeding or clotting. It may be ordered along with a PT (Prothrombin Time) test to evaluate hemostasis (the process of clot formation). The PTT evaluates the coagulation factors XII, XI, IX, VIII, X, V, II (prothrombin), and I (fibrinogen). A PT test evaluates the coagulation factors VII, X, V, II, and I (fibrinogen). By evaluating the results of the two tests together, a doctor can gain clues as to what bleeding or clotting disorder may be present. n These tests are used to monitor heparin anticoagulant therapy. Heparin is a drug that is given intravenously (IV) or by injection to prevent and to treat blood clots. IV’s are also flushed with heparin to prevent clot formation. When it is administered for therapeutic purposes, it must be closely monitored. If too much is given, the treated person may bleed excessively; with too little, the treated person may continue to clot. 92

Complete Blood Count (CBC) n n n The complete blood count or CBC test is used as a broad screening test to check for such disorders as anemia, infection, and many other diseases. It is actually a panel of tests that examines different parts of the blood and includes the following: White blood cell (WBC) count White blood cell differential Red blood cell (RBC) count Hemoglobin Hematocrit platelet count , PTT Mean corpuscular volume (MCV) Mean corpuscular hemoglobin (MCH) Mean corpuscular hemoglobin concentration (MCHC) Red cell distribution width (RDW) 93

Life span, from longest-lived to shortest-lived: n Lymphocytes n Erythrocytes n Platelets n Neutrophils 94

Septicemia (aka bacteremia) is the condition when bacteria invade the body and circulate in the blood. n Bacteria can enter the bloodstream as a severe complication of infections (like pneumonia or meningitis), during surgery (especially when involving mucous membranes such as the gastrointestinal tract), or due to catheters and other foreign bodies entering the arteries or veins (including intravenous drug abuse). n Bacteremia can have several consequences. The immune response to the bacteria can cause sepsis and septic shock, which has a relatively high mortality rate (kills 1 person in 5). Bacteria can also use the blood to spread to other parts of the body (which is called hematogenous spread), causing infections away from the original site of infection. Examples include endocarditis or osteomyelitis. n Treatment is with antibiotics, and prevention with antibiotic prophylaxis can be given in situations where problems are to be expected. n 95

96

Blood Cell Formation n Hematopoiesis – process by which blood cells are formed n 100 billion new blood cells formed each day n The plasma proteins are made in the liver. n The blood cells are made in the red bone marrow. 97

RED BONE MARROW n Most blood cells mature in the red bone marrow. n When they are almost completely mature, they are released into the bloodstream. n When they are old, they are destroyed in the spleen and liver. 98

99

Cell Lines in Blood Cell Formation n All blood cells originate in bone marrow n All originate from one cell type – blood stem cell – Erythroblasts – give rise to red blood cells – Lymphoblasts – give rise to lymphocytes – Myeloblasts – give rise to all other white blood cells 100

Stages of Differentiation of Red Blood Cells 101

RBC Development ERYTHROBLASTS mature until they are ready to enter the circulation. The nucleus gets pinched off as it enters the blood vessel. n When a RBC loses its nucleus, it gains room for more hemoglobin. n Some bits of its nucleus are still there for about 2 days, so during this time, they are called RETICULOCYTES. n 102

ERYTHROBLASTS n These mature into RETICULOCYTES, a RBC with bits of nucleus material, which later dissolves to make room for more Hgb. It is now called an ERYTHROCYTE. 103

LYMPHOBLASTS Give rise to lymphocytes 104

MYELOBLASTS These are the stem cells that mature into the other leukocytes: Neutrophil, macrophage, eosinophil, basophil, platelets. 105

Leukemia is cancer of the stem cells. See all these different types of stem cells? That’s about how many types of leukemia there are. 106

Stages of Differentiation of White Blood Cells Figure 107 17. 9

IMMUNE SYSTEM INFLAMMATORY REACTION: When you get stuck by a thorn or have an infected cut, the body goes through a series of events called an inflammatory reaction. n Four outward signs: n – – Redness (erythema or rubor) Heat (calor) Swelling (edema) Pain (dolor) 108

INFLAMMATORY REACTION n n Redness is caused from the blood vessels dilating to allow more blood flow to the area. Heat is caused because of the extra amount of warm blood flow to the area. Swelling is caused from the plasma that leaks out of the swollen blood vessels. Pain is caused from the pressure of the extra fluid pressing on nerves in the area. 109
a28bdee8531f430294b065528a616420.ppt